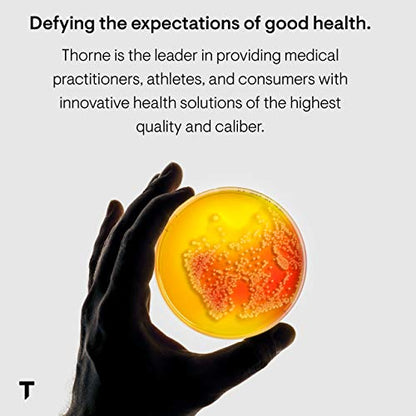

THORNE
Thorne Meta-Balance - Nutritional Support for Women During Menopause - 60 Capsules
Thorne Meta-Balance - Nutritional Support for Women During Menopause - 60 Capsules
Couldn't load pickup availability
Brand: THORNE
Features:
- Menopause: A natural approach to menopause*
- Hormones: Helps balance the normal slowing down of hormones*
- Positivity: Supports a healthy outlook*
- Perfect Pair: Use with Women's Multi 50+, Thorne's multi for women over 50
- Trusted: Thorne is chosen by champions and trusted by 100+ pro teams. Thorne is the only supplement manufacturer to collaborate with Mayo Clinic on wellness research and content. Thorne is also a proud partner of 11 U.S. Olympic Teams
Binding: Health and Beauty
Part Number: SF711
Details: For women who need nutritional support during menopause. Since 1984, Thorne has set the standard for the exceptional formulation and quality manufacturing of nutritional supplements. Thorne delivers premium, science-based products, a health diagnostics technology platform, and the latest in medical education. With more than 350 products, Thorne is the most dispensed brand by 30-40 year old health-care practitioners. Thorne is dedicated to improving the health of our community as well as increasing the knowledge of nutritional health and wellness. Since 2012, Thorne has partnered with educational institutes and local charities to donate more than $1M in products and profits. Thorne products do not contain any unnecessary binders, coatings, disintegrants, fillers, or lubricants (including magnesium stearate) that could impair absorption. Thorne adheres to the FDAÕs current Good Manufacturing Practices (cGMPs) and has the highest number of NSF Certified for Sport products which tests for more than 200 banned substances for elite athletic competitions.
EAN: 0693749711032
Package Dimensions: 3.7 x 1.9 x 1.9 inches
Share